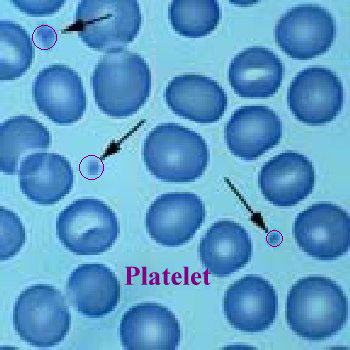
صورة الأعشاب

|
|
| البحث في الاقسام عدد نتايج البحث 0 مقسمة في 0 صفحات | |||
| اسم البحث | عدد المواد | الزوار | |
|
|
| البحث في المواد عدد نتايج البحث 1 مقسمة في 1 صفحات | |||
| اسم البحث | القسم | الزوار | |
| البلازما: ثورة طبية في تجديد الأنسجة وعلاج الأمراض | مقالات وابحاث طبية وعلمية | 1745 | المقالات الطبية |
|
|
|
|
|
|
|
|
|
|
|
|
|
|
|
|
|
|
|
|
|